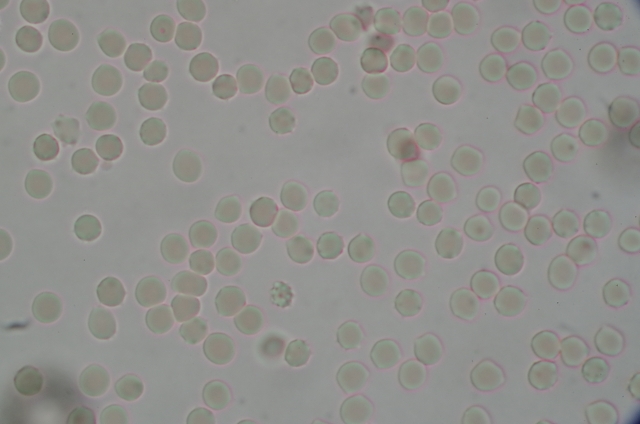

尿検査は、痛みもなく「腎臓・糖尿病・尿路の異常」を早期発見できる、最もコストパフォーマンスの高い検査の一つです。
前回は尿蛋白について解説しました。今回は尿潜血について解説します。
「血尿が出てますね」、健康診断で指摘されたことがある経験はありませんか?
女性の場合は生理中で尿検査をすると、生理の血液が混ざってしまって尿の中に血液が検出することがあります。
また膀胱炎でも尿の中に血液がよく混ざります。
尿蛋白と違って、尿潜血があっても「腎臓が悪い」のか、腎臓から先の「尿が通る通り道に異常がある」のか、これだけでは判断できません。
また必ずしも病的でない場合もあります。
今回は、尿潜血陽性について内科医師の視点から、どのようなことを考えて、追加検査をしていくのかを解説していきます。
尿潜血(+)は「病気」ではなく「サイン」
放置は厳禁ですが、過度な不安も不要です。
重要なのは「顕微鏡的血尿=尿潜血」の裏にある原因を特定し、リスクの層別化を行うことです。
尿が明らかに赤くて血液が混ざっていることを「肉眼的血尿」と言います。
この場合は腎臓自体に病気があるよりも、尿路のどこからか出血している場合=泌尿器科的疾患がほとんどになります。
尿潜血が陽性になる3つの主要因
尿潜血(+)は、尿中に赤血球が混じっている状態(血尿)を示唆します。
原因は大きく分けて以下の3つです。
- 一過性の要因(良性): 激しい運動、脱水、生理、発熱など。これらは一時的なもので、再検査すると陰性化していることもあります。
- 泌尿器科的疾患: 尿路結石、膀胱炎、前立腺肥大症、そして最も警戒すべき「尿路悪性腫瘍(癌)」が含まれます。
- 内科的疾患(腎臓): 糸球体腎炎など、腎臓のろ過機能自体に問題があるケースです。蛋白尿も伴う場合はこちらの可能性が高まります。
受診後の検査フローと診断の要点
「+」が出た場合、まずは「尿沈渣(にょうちんさ)」という精密な顕微鏡検査で、実際に赤血球が基準値を超えているかを確認します。
さらに以下のようにほかの検査を併用していきます。
| 検査項目 | 目的 | 備考 |
| 尿沈渣 | 赤血球の数と形を確認 | 5個/HPF以上で「血尿」と確定 |
| 腹部エコー | 結石、腫瘍、腎臓の形態確認 | 痛みもなく、情報量が多い第一選択 |
| 尿細胞診 | 尿の中に癌細胞がないか確認 | 悪性腫瘍のスクリーニング |
| 血液検査 | 腎機能(Cre, eGFR)の測定 | 腎不全のリスクを評価 |
今後の見通し:リスクに応じた経過観察
検査の結果、異常がなければ「特発性血尿」として経過観察となります。
- 異常なしの場合: 半年〜1年ごとの定期的な尿検査を継続します。
- 疾患が見つかった場合: 結石なら体外衝撃波や自然排石、腫瘍なら早期手術など、原因疾患に応じた治療へ移行します。
- 特に注意すべき人: 50歳以上、喫煙歴あり、肉眼的血尿(目で見て赤い)を一度でも経験した方は、膀胱鏡検査を含めた精密検査が推奨されます。
たとえ話:火災報知器
尿潜血(+)は「火災報知器が鳴っている状態」です。実際に火事(癌や結石)が起きていることもあれば、ただの誤作動(運動や体調)のこともあります。大切なのは、報知器を無視せず、煙が出ていないか部屋(体内)を確認することです。
実際によくやられる検査の手順は?
無症状で尿潜血陽性の人が来た場合、まずは再検と尿沈渣から確認します。
原因で最も多いのは「特発性」です(70%の頻度、特に病気がなく一時的なもの)。
50歳を超えると尿路悪性疾患の可能性が増加するので、注意が必要です。
発熱や運動のし過ぎなどで筋肉が壊れると、尿沈渣で赤血球がなく、尿潜血(+)となる場合があります。
これは筋肉の成分であるミオグロビンが尿中に排泄されるためで、尿潜血(+)と反応してしまいますが、実際に見ると赤血球がないという状態になります(ミオグロビン尿)。
ほかに赤血球が血管の中で壊される(溶血する)とヘモグロビンという成分になり、これが尿中に出てきても尿潜血(+)となります(ヘモグロビン尿)。
腎・尿路の病気ではなく、一時的な要因も多いので、検査期間と状況を整えて再検すると異常なしになることが多いです。
蛋白尿も一緒に検出された場合は、腎臓自体の病気を考えます。
さらに、尿沈渣で見られる赤血球の形が変形しているのが多い(変形赤血球>70% 以上)と腎臓の異常を疑います。
この場合は腎臓内科中心に精密検査を進めていきます。
最終的に腎生検(腎臓本体の細胞を少量採取して、顕微鏡で調べる)を行って診断を確定する場合もあります。
尿潜血だけ検出し続ける場合は、尿路(尿が通る道)の異常を考えます。
泌尿器科を中心に、尿の通り道にがんができている可能性を念頭に検査を進めていきます。
尿路から出血している場合、尿沈渣で見ることができる赤血球は正常な形で見られることが多いです(変形赤血球<20%)
主に画像検査(超音波、CT、MRIなど)や膀胱鏡を用いて検査を進めます。

まとめ
尿潜血(+)になったとき、どのように考え検査を進めていくかを解説しました。
尿蛋白の時と大きく違うのは、「泌尿器科が中心になって検査を進めていく」可能性があるというところです。
入り口は「内科」のことが多いと思いますが、再検査をして尿潜血が持続している場合は、泌尿器科受診を考えましょう。
男性なら前立腺も含めて精密検査を追加していきます。たとえ癌があっても早期発見なら十分に治療可能な領域です。
症状がなく、正常な人でも一時的に尿潜血(+)になることはよく見られます。持続するような場合は、めんどくさがらずに泌尿器科での診察・検査を受けていくようにしましょう。
次回は、尿検査でほかに何がわかるのか?を解説していきます。
調査参照リファレンス
- 日本泌尿器科学会:血尿診断ガイドライン 2023
- 日本腎臓学会:エビデンスに基づく尿検診異常への対応ガイド
- 厚生労働省:e-ヘルスネット(尿検査の意義)
関連記事:尿検査にもかかわる生活習慣病は、こちらもご覧ください
・尿酸値が高いといわれた時に読んでください:尿酸値が高いと言われたら?原因・食事・放置するリスク・薬の種類まで徹底解説
・【運動とセットで!】糖尿病・食事療法の基本ポイント:食事療法の単位とは? どのくらい食べていいの? 間食は?
・【糖尿病の運動療法】血糖値をコントロールする効果的なやり方と注意点
・健診で行う腹部超音波検査(エコー検査)でわかること:いつごろからやった方がいい? 食事したら検査できないの? ほんとうに痛くない?


コメント